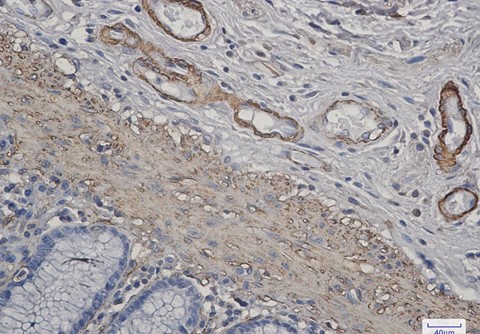

您当前的位置:
muscle Actin (DGR14993) Rabbit mAb (PBS Only)
db14536-PBS
Datasheet
Conjugation/Formulation:PBS Only
- Background The product encoded by this gene belongs to the actin family of proteins, which are highly conserved proteins that play a role in cell motility, structure and integrity. Alpha, beta and gamma actin isoforms have been identified, with alpha actins being a major constituent of the contractile apparatus, while beta and gamma actins are involved in the regulation of cell motility. This actin is an alpha actin that is found in skeletal muscle. Mutations in this gene cause nemaline myopathy type 3, congenital myopathy with excess of thin myofilaments, congenital myopathy with cores, and congenital myopathy with fiber-type disproportion, diseases that lead to muscle fiber defects. [provided by RefSeq, Jul 2008]
- Immunogen A synthetic peptide of human muscle Actin
-
Gene ID
58
-
Swiss Prot
P68133
- Synonyms ACTA; ASMA; CFTD; MPFD; NEM1; NEM2; NEM3; SHPM; CFTD1; CFTDM
- Reactivity Human,Mouse,Rat
- Application WB, IHC-P, ICC/IF, FC, IP
- Calculated MW 42 kDa
- Observed MW 42 kDa
- Host species Rabbit
- Clonality Monoclonal
- Clonality No. DGR14993
- Isotype IgG
- Purity Affinity Purification
- Conjugation Un-conjugated
- Concentration 1 mg/mL
- Formulation PBS Only
- Storage/Stability Store at -20°C. Recommended to aliquot into single-use vials. Supplied in 1X PBS (pH 7.4). BSA and Azide Free. Stable for 12 months from date of receipt.
-
 Western blot analysis of extracts from HeLa cells using db14536 at 1:1000.
Western blot analysis of extracts from HeLa cells using db14536 at 1:1000. -
Immunohistochemical analysis of paraffin-embedded human colon cancer using db14536 antibody.
Immunohistochemical analysis of paraffin-embedded human colon cancer using db14536 antibody. -
 Immunofluorescent analysis of HeLa cells using db14536 antibody (green), and DAPI (blue).
Immunofluorescent analysis of HeLa cells using db14536 antibody (green), and DAPI (blue). -
 Western blot analysis of extracts from Rat muscle tissue using db14536 at 1:1000.
Western blot analysis of extracts from Rat muscle tissue using db14536 at 1:1000.
订购信息
- Package Price (RMB)
- 10μg 1898
- 100μg 5798
- 货期:现货
相关产品
For research use only. Not intended for diagnostic.
